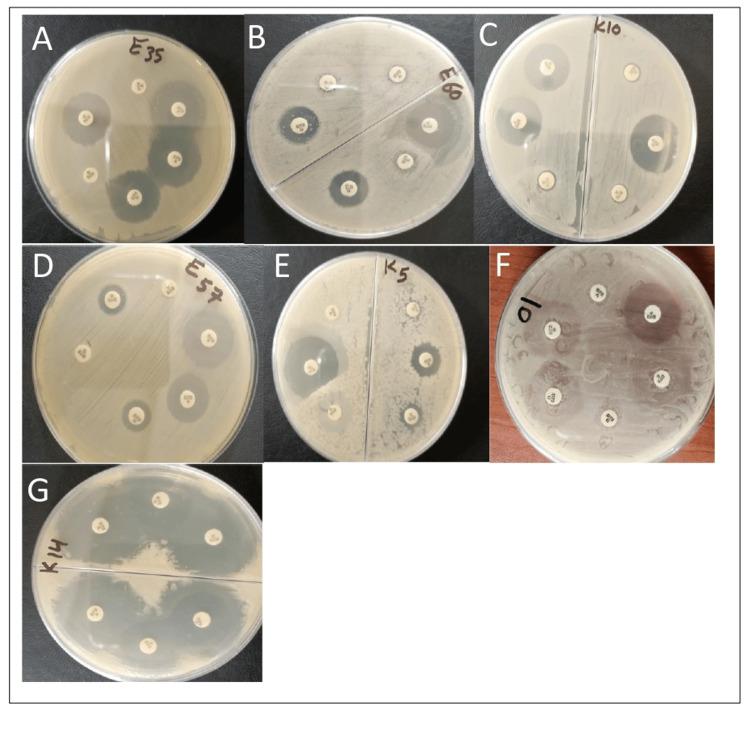
https://cdn.ncbi.nlm.nih.gov/pmc/blobs/b215/11808409/ba2290b34420/cureus-0017-00000077269-i01.jpg

使用MASTDISCS®组合D72C试剂盒对大肠杆菌和肺炎克雷伯菌中的超广谱β-内酰胺酶、AmpCβ-内酰胺酶和碳青霉烯酶进行表型检测的分子评估
Molecular Assessment Using the MASTDISCS® Combi D72C Set for the Phenotypic Detection of Extended-Spectrum Beta-Lactamases, AmpC Beta-Lactamases, and Carbapenemase Enzymes in Escherichia coli and Klebsiella pneumoniae.
作者信息
Haji Sayran H, Ganjo Aryan R, Abdulaziz Sazan Moffaq, Abdullah Zheen A, Smail Sakar B
机构信息
Department of Clinical Analysis, College of Pharmacy, Hawler Medical University, Erbil, IRQ.
Department of Medical Analysis, Faculty of Applied Science, Tishk International University, Erbil, IRQ.
出版信息
Cureus. 2025 Jan 11;17(1):e77269. doi: 10.7759/cureus.77269. eCollection 2025 Jan.
Beta-lactam resistance poses a global issue and a considerable challenge to effective antimicrobial therapy. The study aimed to ascertain the phenotypic and genotype traits of carbapenemase, extended-spectrum beta (β)-lactamases (ESBL), and AmpC β-lactamase-producing isolates collected from hospitals. A range of clinical samples consisted of 63 ) and 30 isolates. Phenotypic characterization was carried out utilizing the MASTDISCS® Combi ESBL, AmpC, and carbapenemase detection set-D72C (Mast Group Ltd, Bootle, United Kingdom). Molecular assays were used to detect carbapenemase, ESBL, and AmpC genes. Both and clinical isolates exhibited noticeably enhanced resistance to β-lactam antibiotics. MASTDISCS® Combi D72C phenotype detection tests revealed that 57 (90.6%) and 30 (100%) isolates produced ESBL and AmpC enzymes, with evidence of carbapenemase activity. The majority of isolates had at least one β-lactamase-related gene. Based on molecular findings, the majority of ESBL-producing isolates in both pathogens had 17 (56.6%) of the bla gene in and 16 (53.3%) of the bla gene in both pathogens. The AmpC-associated genes, both bla and bla, were exposed in five (16.6%) isolates and nine (30%) and 10 (33.3%) among respectively. In terms of the carbapenemase gene, bla was the most prevalent gene, appearing in 20 (66.6%) of the two pathogens.This study demonstrated that and that produceβ-lactamases have emergedas pathogens linked to infections in healthcare settings. Accurate identification of β-lactamase-producing bacterial pathogens is essential for patient treatment. We observed co-expression of AmpC, carbapenemase, and ESBL genes in most isolates, indicating a need to implement modern plans against these pathogens.
β-内酰胺耐药性是一个全球性问题,对有效的抗菌治疗构成了相当大的挑战。该研究旨在确定从医院收集的产碳青霉烯酶、超广谱β-内酰胺酶(ESBL)和AmpCβ-内酰胺酶分离株的表型和基因型特征。一系列临床样本包括63株(此处原文“63 )”表述有误,推测为63株)和30株分离株。使用MASTDISCS®Combi ESBL、AmpC和碳青霉烯酶检测套装-D72C(Mast Group Ltd,英国布特尔)进行表型鉴定。分子检测用于检测碳青霉烯酶、ESBL和AmpC基因。(此处原文“Both and clinical isolates”表述有误,推测为两种临床分离株)两种临床分离株对β-内酰胺类抗生素均表现出明显增强的耐药性。MASTDISCS®Combi D72C表型检测试验显示,57株(90.6%)(此处原文有误,推测为两种病原体中的一种的57株)和30株(100%)(此处原文有误,推测为另一种病原体的30株)分离株产生ESBL和AmpC酶,并具有碳青霉烯酶活性证据。大多数分离株至少有一个β-内酰胺酶相关基因。基于分子检测结果,两种病原体中产ESBL的分离株中,大多数在一种病原体中有17株(56.6%)携带bla基因,在另一种病原体中有16株(53.3%)携带bla基因。与AmpC相关的基因,bla和bla,分别在5株(16.6%)一种病原体的分离株、9株(30%)和10株(33.3%)另一种病原体的分离株中被检测到。就碳青霉烯酶基因而言,bla是最常见的基因,出现在两种病原体的20株(66.6%)中。本研究表明,产β-内酰胺酶的两种病原体已成为与医疗环境中感染相关的病原体。准确鉴定产β-内酰胺酶的细菌病原体对患者治疗至关重要。我们观察到大多数分离株中AmpC、碳青霉烯酶和ESBL基因共表达,这表明需要实施针对这些病原体的现代防控方案。